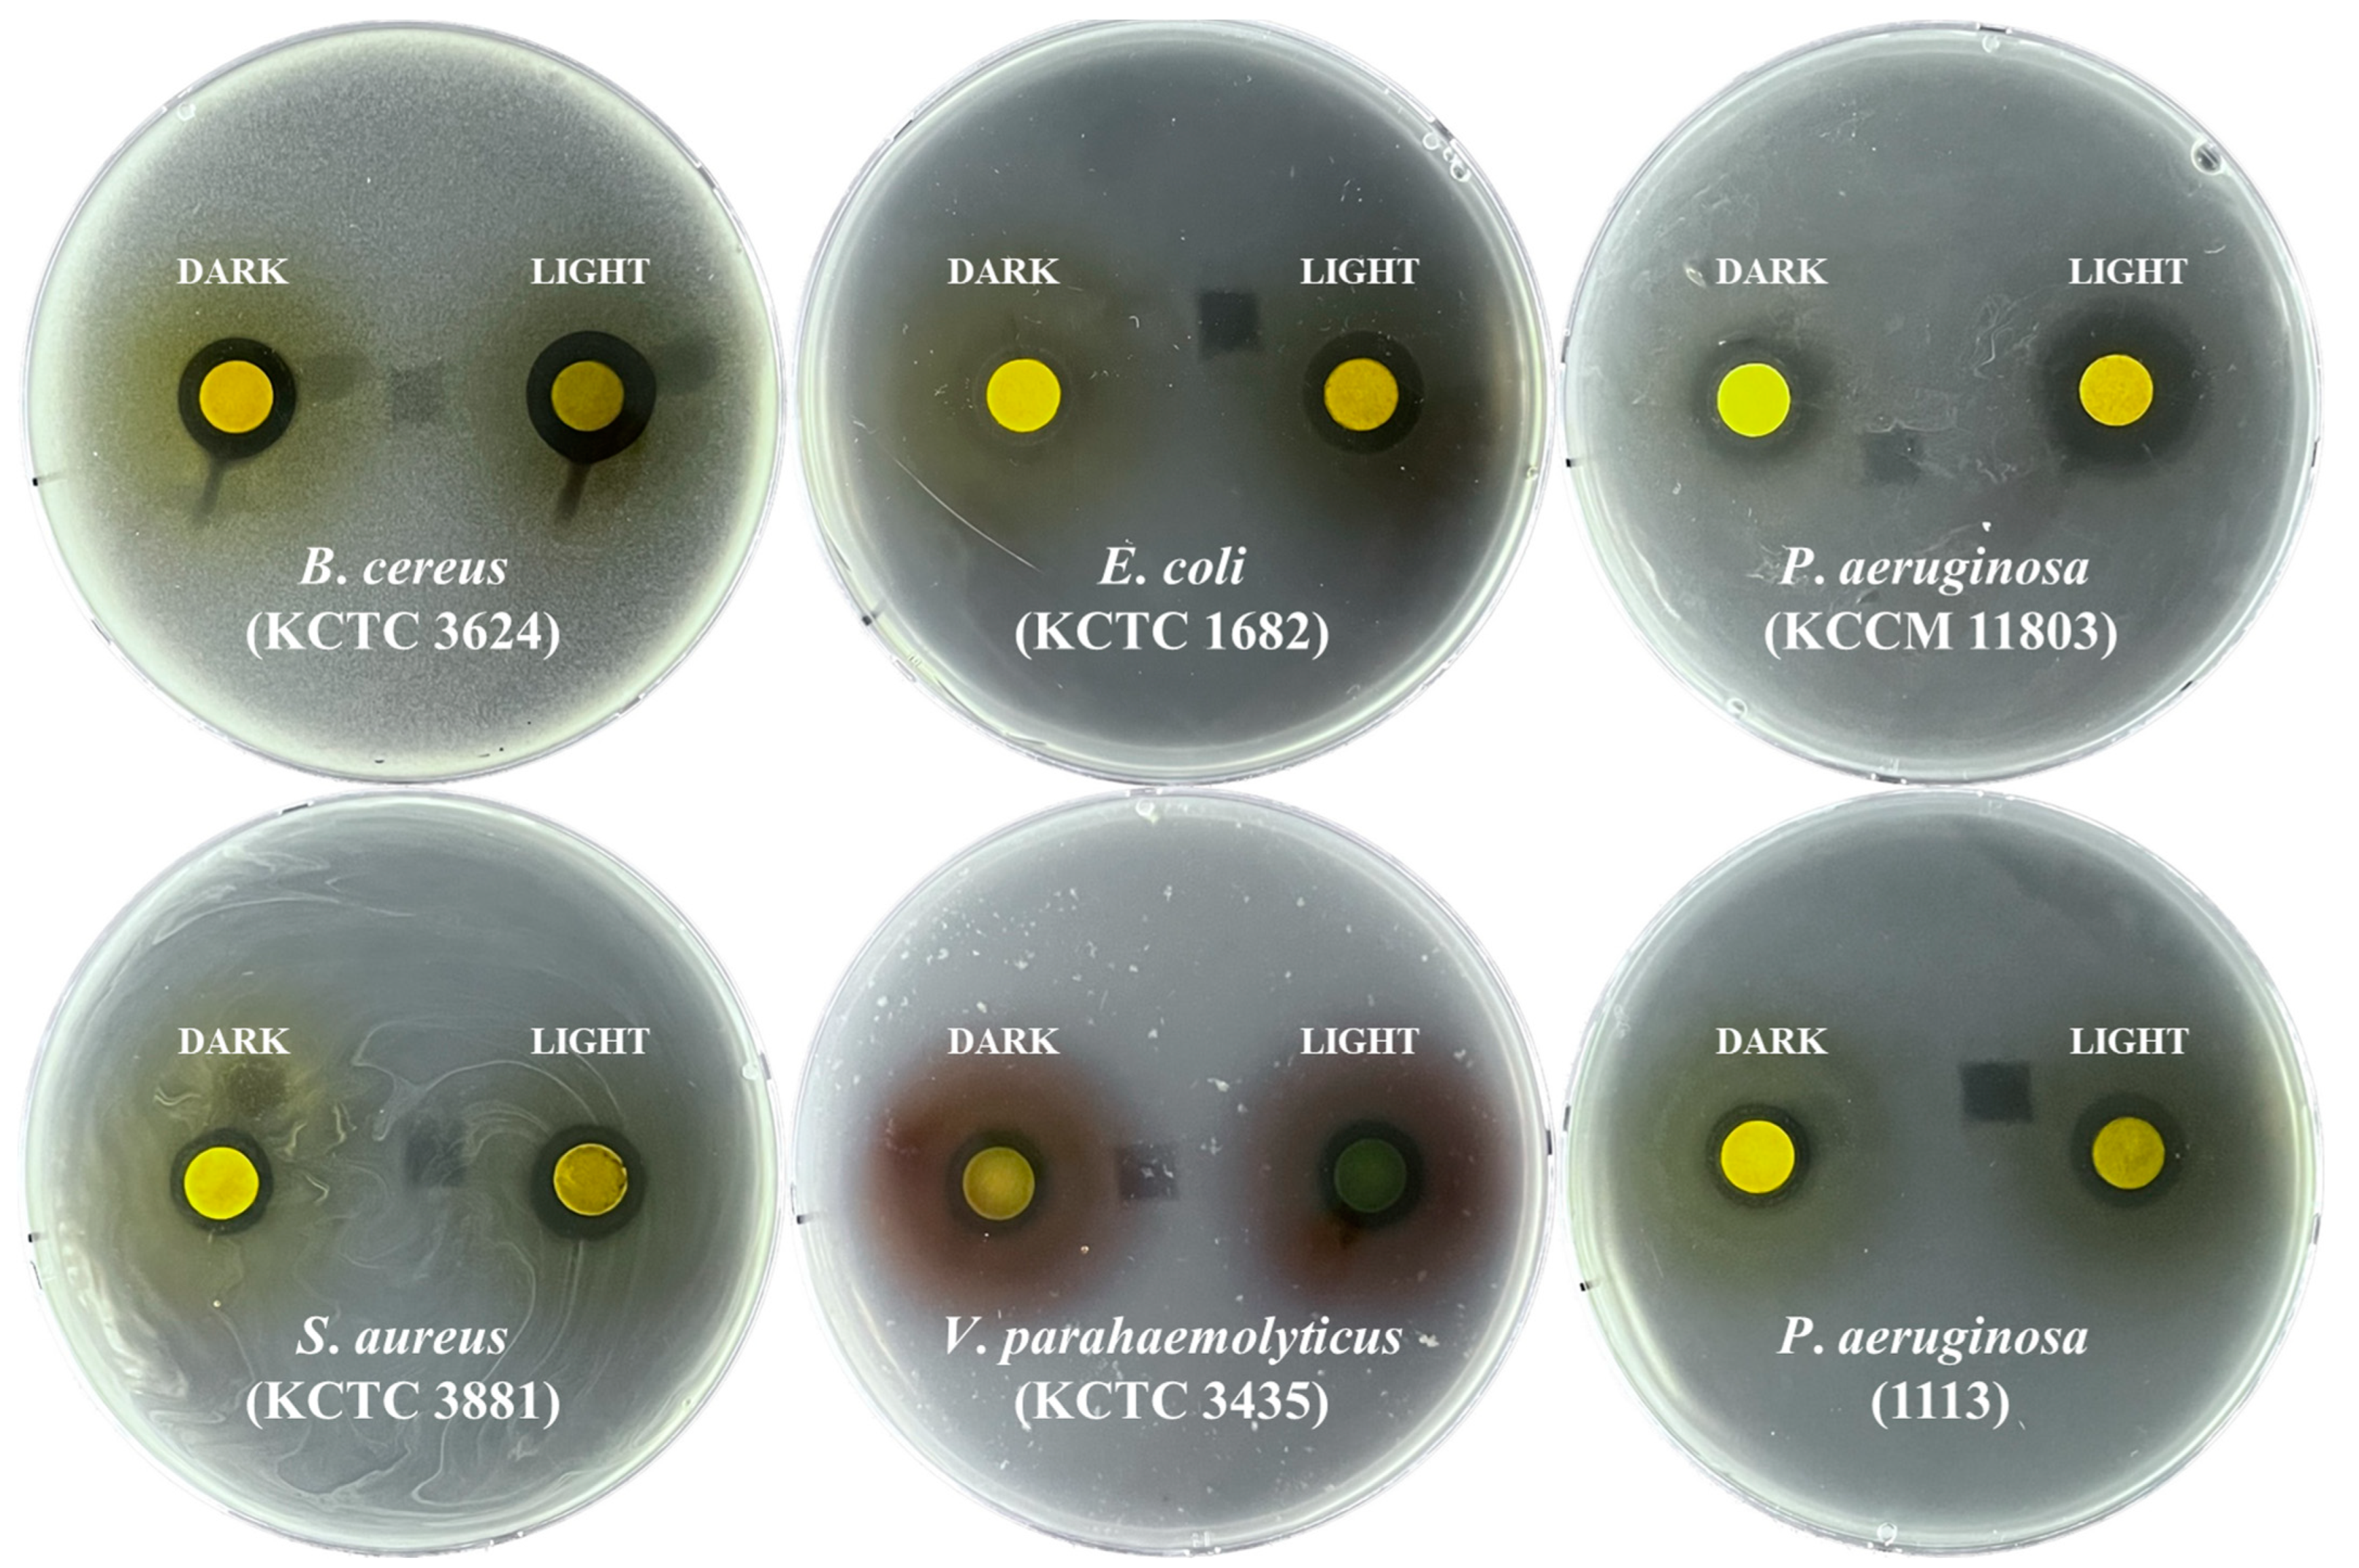
Plants 12 01613 g002

The Effect of Light and Dark Treatment on the Production of Rosmarinic Acid and Biological Activities in Perilla frutescens Microgreens
Abstract
1. Introduction
2. Results
2.1. P. frutescens Microgreen Production
2.2. Rosmarinic Acid Production and Total Phenolic Contents in P. frutescens Microgreens
2.3. In Vitro Antibacterial Properties of Methanol Extracts of P. frutescens Microgreens for 20 Days of Long-Day Photoperiod or Continuous Darkness Conditions
3. Discussion
4. Materials and Methods
4.1. P. frutescens Microgreen Production
4.2. High-Performance Liquid Chromatography and Determination of Total Phenolic Content
4.3. In Vitro Antioxidant Activity
4.4. Screening for Antibacterial Activity
4.5. Statistical Analysis
4.6. Chemicals
5. Conclusions
Author Contributions
Funding
Data Availability Statement
Conflicts of Interest
References
- Kim, D.-H.; Kim, S.J.; Yu, K.-Y.; Jeong, S.-I.; Kim, S.-Y. Anti-hyperglycemic effects and signaling mechanism of Perilla frutescens sprout extract. Nutr. Res. Pract. 2018, 12, 20–28. [Google Scholar] [CrossRef]
- Hou, T.; Netala, V.R.; Zhang, H.; Xing, Y.; Li, H.; Zhang, Z. Perilla frutescens: A rich source of pharmacological active compounds. Molecules 2022, 27, 3578. [Google Scholar] [CrossRef] [PubMed]
- Xu, Y.; Shi, Y.; Huang, J.; Gu, H.; Li, C.; Zhang, L.; Liu, G.; Zhou, W.; Du, Z. The Essential Oil Derived from Perilla frutescens (L.) Britt. Attenuates Imiquimod–Induced Psoriasis-like Skin Lesions in BALB/c Mice. Molecules 2022, 27, 2996. [Google Scholar] [CrossRef]
- Ahmed, H.M. Ethnomedicinal, phytochemical and pharmacological investigations of Perilla frutescens (L.) Britt. Molecules 2018, 24, 102. [Google Scholar] [CrossRef]
- Lee, J.H.; Cho, Y.-S. Assessment of phenolic profiles from various organs in different species of perilla plant (Perilla frutescens (L.) Britt.) and their antioxidant and enzyme inhibitory potential. Ind. Crops Prod. 2021, 171, 113914. [Google Scholar] [CrossRef]
- Ueda, H.; Yamazaki, C.; Yamazaki, M. Inhibitory effect of Perilla leaf extract and luteolin on mouse skin tumor promotion. Biol. Pharm. Bull. 2003, 26, 560–563. [Google Scholar] [CrossRef] [PubMed]
- Makino, T.; Furuta, Y.; Wakushima, H.; Fujii, H.; Saito, K.i.; Kano, Y. Anti-allergic effect of Perilla frutescens and its active constituents. Phytother. Res. 2003, 17, 240–243. [Google Scholar] [CrossRef] [PubMed]
- Reddy, N.; Li, H.; Hou, T.; Bethu, M.; Ren, Z.; Zhang, Z. Phytosynthesis of silver nanoparticles using Perilla frutescens leaf extract: Characterization and evaluation of antibacterial, antioxidant, and anticancer activities. Int. J. Nanomed. 2021, 16, 15. [Google Scholar] [CrossRef]
- Zhou, X.-J.; Yan, L.-L.; Yin, P.-P.; Shi, L.-L.; Zhang, J.-H.; Liu, Y.-J.; Ma, C. Structural characterisation and antioxidant activity evaluation of phenolic compounds from cold-pressed Perilla frutescens var. arguta seed flour. Food Chem. 2014, 164, 150–157. [Google Scholar] [CrossRef] [PubMed]
- Oh, H.-A.; Park, C.-S.; Ahn, H.-J.; Park, Y.S.; Kim, H.-M. Effect of Perilla frutescens var. acuta Kudo and rosmarinic acid on allergic inflammatory reactions. Exp. Biol. Med. 2011, 236, 99–106. [Google Scholar] [CrossRef] [PubMed]
- Li, H.-Z.; Ren, Z.; Reddy, N.; Hou, T.; Zhang, Z.-J. In silico evaluation of antimicrobial, antihyaluronidase and bioavailability parameters of rosmarinic acid in Perilla frutescens leaf extracts. SN Appl. Sci. 2020, 2, 1–14. [Google Scholar] [CrossRef]
- Lin, C.-S.; Kuo, C.-L.; Wang, J.-P.; Cheng, J.-S.; Huang, Z.-W.; Chen, C.-F. Growth inhibitory and apoptosis inducing effect of Perilla frutescens extract on human hepatoma HepG2 cells. J. Ethnopharmacol. 2007, 112, 557–567. [Google Scholar] [CrossRef] [PubMed]
- Alfieri, A.; Mann, G.E. Bioactive Nutraceuticals and Stroke: Activation of Endogenous Antioxidant Pathways and Molecular Mechanisms Underlying Neurovascular Protection. In Bioactive Nutraceuticals and Dietary Supplements in Neurological and Brain Disease; Elsevier: Amsterdam, The Netherlands, 2015; pp. 365–379. [Google Scholar]
- Trócsányi, E.; György, Z.; Zámboriné-Németh, É. New insights into rosmarinic acid biosynthesis based on molecular studies. Curr. Plant Biol. 2020, 23, 100162. [Google Scholar] [CrossRef]
- Nadeem, M.; Imran, M.; Aslam Gondal, T.; Imran, A.; Shahbaz, M.; Muhammad Amir, R.; Wasim Sajid, M.; Batool Qaisrani, T.; Atif, M.; Hussain, G. Therapeutic potential of rosmarinic acid: A comprehensive review. Appl. Sci. 2019, 9, 3139. [Google Scholar] [CrossRef]
- Park, C.H.; Kim, N.S.; Park, J.S.; Lee, S.Y.; Lee, J.-W.; Park, S.U. Effects of light-emitting diodes on the accumulation of glucosinolates and phenolic compounds in sprouting canola (Brassica napus L.). Foods 2019, 8, 76. [Google Scholar] [CrossRef]
- Ebert, A.W. Sprouts and microgreens—Novel food sources for healthy diets. Plants 2022, 11, 571. [Google Scholar] [CrossRef]
- Dimita, R.; Min Allah, S.; Luvisi, A.; Greco, D.; De Bellis, L.; Accogli, R.; Mininni, C.; Negro, C. Volatile Compounds and Total Phenolic Content of Perilla frutescens at Microgreens and Mature Stages. Horticulturae 2022, 8, 71. [Google Scholar] [CrossRef]
- Pająk, P.; Socha, R.; Broniek, J.; Królikowska, K.; Fortuna, T. Antioxidant properties, phenolic and mineral composition of germinated chia, golden flax, evening primrose, phacelia and fenugreek. Food Chem. 2019, 275, 69–76. [Google Scholar] [CrossRef] [PubMed]
- Hong, J.; Gruda, N.S. The potential of introduction of Asian vegetables in Europe. Horticulturae 2020, 6, 38. [Google Scholar] [CrossRef]
- Carvalho, S.D.; Folta, K.M. Sequential light programs shape kale (Brassica napus) sprout appearance and alter metabolic and nutrient content. Hortic. Res. 2014, 1, 8. [Google Scholar] [CrossRef]
- Rodríguez-Villalón, A.; Gas, E.; Rodríguez-Concepción, M. Colors in the dark: A model for the regulation of carotenoid biosynthesis in etioplasts. Plant Signal. Behav. 2009, 4, 965–967. [Google Scholar] [CrossRef] [PubMed]
- Mastropasqua, L.; Dipierro, N.; Paciolla, C. Effects of darkness and light spectra on nutrients and pigments in radish, soybean, mung bean and pumpkin sprouts. Antioxidants 2020, 9, 558. [Google Scholar] [CrossRef] [PubMed]
- Siriparu, P.; Panyatip, P.; Pota, T.; Ratha, J.; Yongram, C.; Srisongkram, T.; Sungthong, B.; Puthongking, P. Effect of Germination and Illumination on Melatonin and Its Metabolites, Phenolic Content, and Antioxidant Activity in Mung Bean Sprouts. Plants 2022, 11, 2990. [Google Scholar] [CrossRef] [PubMed]
- Nam, T.G.; Kim, D.-O.; Eom, S.H. Effects of light sources on major flavonoids and antioxidant activity in common buckwheat sprouts. Food Sci. Biotechnol. 2018, 27, 169–176. [Google Scholar] [CrossRef]
- Xiang, N.; Guo, X.; Liu, F.; Li, Q.; Hu, J.; Brennan, C.S. Effect of light-and dark-germination on the phenolic biosynthesis, phytochemical profiles, and antioxidant activities in sweet corn (Zea mays L.) sprouts. Int. J. Mol. Sci. 2017, 18, 1246. [Google Scholar] [CrossRef]
- Kim, H.E.; Yun, H.R.; Heo, J.B. Comparative analysis of functional compounds in Perilla frutescens at different stages and growth times. J. Life Sci. 2021, 31, 511–519. [Google Scholar]
- Cao, H.; Cheng, W.-X.; Li, C.; Pan, X.-L.; Xie, X.-G.; Li, T.-H. DFT study on the antioxidant activity of rosmarinic acid. J. Mol. Struct. THEOCHEM 2005, 719, 177–183. [Google Scholar] [CrossRef]
- Lim, H.; Shin, S. Anti-Bacillus and Anti-Shigella Activities of the Essential Oil from Perilla fruescens var. japonica Hara. J. Essent. Oil Bear. Plants 2014, 17, 309–316. [Google Scholar] [CrossRef]
- Ghimire, B.K.; Yoo, J.H.; Yu, C.Y.; Kim, S.-H.; Chung, I.-M. Profiling volatile and phenolic compound composition and characterization of the morphological and biological activities of Perilla frutescence Britton var. Japonica accessions. Acta Physiol. Plant. 2019, 41, 1–16. [Google Scholar] [CrossRef]
- Kim, D.-H.; Kim, Y.-C.; Choi, U.-K. Optimization of antibacterial activity of Perilla frutescens var. acuta leaf against Staphylococcus aureus using evolutionary operation factorial design technique. Int. J. Mol. Sci. 2011, 12, 2395–2407. [Google Scholar] [CrossRef] [PubMed]
- Jeong, H.J.; Xuan, S.H.; Song, B.R.; Lee, S.L.; Lee, Y.J.; Park, S.N. Antimicrobial and antioxidant activities of Perilla frutescens var. acuta extract and its fraction and their component analyses. Appl. Chem. Eng. 2018, 29, 716–725. [Google Scholar]
- Lim, H.-R.; Shin, S.-W. Activities of essential oils from Perilla frutescens var. acuta against antibiotic-susceptible and-resistant Vibrio and Salmonella species. Nat. Prod. Sci. 2011, 17, 296–302. [Google Scholar]
- Mahizan, N.A.; Yang, S.-K.; Moo, C.-L.; Song, A.A.-L.; Chong, C.-M.; Chong, C.-W.; Abushelaibi, A.; Lim, S.-H.E.; Lai, K.-S. Terpene derivatives as a potential agent against antimicrobial resistance (AMR) pathogens. Molecules 2019, 24, 2631. [Google Scholar] [CrossRef] [PubMed]
- Ahmed, H.M.; Al-Zubaidy, A.M.A. Exploring natural essential oil components and antibacterial activity of solvent extracts from twelve Perilla frutescens L. Genotypes. Arab. J. Chem. 2020, 13, 7390–7402. [Google Scholar] [CrossRef]
- Yeo, H.J.; Park, C.H.; Park, Y.E.; Hyeon, H.; Kim, J.K.; Lee, S.Y.; Park, S.U. Metabolic profiling and antioxidant activity during flower development in Agastache rugosa. Physiol. Mol. Biol. Plants 2021, 27, 445–455. [Google Scholar] [CrossRef]
- Park, C.H.; Yeo, H.J.; Park, C.; Chung, Y.S.; Park, S.U. The effect of different drying methods on primary and secondary metabolites in Korean mint flower. Agronomy 2021, 11, 698. [Google Scholar] [CrossRef]
- Park, C.H.; Yeo, H.J.; Park, Y.E.; Kim, Y.J.; Park, C.; Kim, J.K.; Park, S.U. Integrated analysis of transcriptome and metabolome and evaluation of antioxidant activities in Lavandula pubescens. Antioxidants 2021, 10, 1027. [Google Scholar] [CrossRef]
- Yeo, H.J.; Kwon, M.J.; Han, S.Y.; Jeong, J.C.; Kim, C.Y.; Park, S.U.; Park, C.H. Effects of Carbohydrates on Rosmarinic Acid Production and In Vitro Antimicrobial Activities in Hairy Root Cultures of Agastache rugosa. Plants 2023, 12, 797. [Google Scholar] [CrossRef]

| Exposure Time (d) | Dry Weight (g) | |
|---|---|---|
| Light | Dark | |
| 10 days | 0.51 ± 0.05 c 1 | 0.49 ± 0.18 b |
| 15 days | 0.86 ± 0.08 b | 0.71 ± 0.05 ab |
| 20 days | 1.01 ± 0.10 a | 0.90 ± 0.16 a |
| 25 days | 0.99 ± 0.05 ab | 0.87 ± 0.12 a |
| Treatment | Duration | Rosmarinic Acid (mg/g Dry Weight) |
|---|---|---|
| Dark | 10 days | 9.01 ± 7.36 b 1 |
| 15 days | 13.01 ± 2.82 b | |
| 20 days | 22.66 ± 0.55 a | |
| 25 days | 13.75 ± 20.68 b | |
| Light | 10 days | 21.89 ± 0.80 a |
| 15 days | 20.18 ± 1.40 a | |
| 20 days | 21.08 ± 1.20 a | |
| 25 days | 20.68 ± 2.93 a |
| Light | Dark | |||||||
|---|---|---|---|---|---|---|---|---|
| 10 Days | 15 Days | 20 Days | 25 Days | 10 Days | 15 Days | 20 Days | 25 Days | |
| Total phenolics [mg gallic acid equivalent (GAE)/g Dry weight] | 2.52 ± 0.23 a 1 | 2.43 ± 0.04 a | 2.59 ± 0.24 a | 2.64 ± 0.37 a | 1.08 ± 0.59 b | 1.49 ± 0.16 ab | 2.64 ± 0.77 a | 1.39 ± 0.80 b |
| DPPH (inhibition%) | 95.97 ± 0.04 a | 95.54 ± 0.14 ab | 95.32 ± 0.47 b | 95.37 ± 0.39 ab | 94.51 ± 0.32 c | 95.09 ± 0.21 b | 95.87 ± 0.25 a | 94.43 ± 0.07 c |
| Group | Bacterial Strains | Zone of Inhibition (mm) | |
|---|---|---|---|
| Extracts from P. frutescens Microgreens after 20 Days of Light Exposure | Extracts from P. frutescens Microgreens after 20 Days of Dark Exposure | ||
| Pathogens | B. cereus (KCTC 3624) | 12–13 | 13–14 |
| E. coli (KCTC 1682) | 10–11 | 13–14 | |
| P. aeruginosa (KCCM 11803) | 13–14 | 17–18 | |
| S. aureus (KCTC 3881) | 11–12 | 12–13 | |
| V. parahaemolyticus (KCTC 2471) | 10–11 | 12–13 | |
| S. paratyphi C (KCCM 41577) | ─ 1 | ─ | |
| S. mutans (KCTC 3065) | ─ | ─ | |
| M. luteus (KCTC 3063) | ─ | ─ | |
| Multidrug resistant pathogens | P. aeruginosa (1113) | 11–12 | 13–14 |
Disclaimer/Publisher’s Note: The statements, opinions and data contained in all publications are solely those of the individual author(s) and contributor(s) and not of MDPI and/or the editor(s). MDPI and/or the editor(s) disclaim responsibility for any injury to people or property resulting from any ideas, methods, instructions or products referred to in the content. |
© 2023 by the authors. Licensee MDPI, Basel, Switzerland. This article is an open access article distributed under the terms and conditions of the Creative Commons Attribution (CC BY) license (https://creativecommons.org/licenses/by/4.0/).
Share and Cite
Lee, S.; Yeo, H.J.; Lee, S.Y.; Kim, S.R.; Park, S.U.; Park, C.H. The Effect of Light and Dark Treatment on the Production of Rosmarinic Acid and Biological Activities in Perilla frutescens Microgreens. Plants 2023, 12, 1613. https://doi.org/10.3390/plants12081613
Lee S, Yeo HJ, Lee SY, Kim SR, Park SU, Park CH. The Effect of Light and Dark Treatment on the Production of Rosmarinic Acid and Biological Activities in Perilla frutescens Microgreens. Plants. 2023; 12(8):1613. https://doi.org/10.3390/plants12081613
Chicago/Turabian StyleLee, Seom, Hyeon Ji Yeo, Sang Yeob Lee, Su Ryang Kim, Sang Un Park, and Chang Ha Park. 2023. "The Effect of Light and Dark Treatment on the Production of Rosmarinic Acid and Biological Activities in Perilla frutescens Microgreens" Plants 12, no. 8: 1613. https://doi.org/10.3390/plants12081613
APA StyleLee, S., Yeo, H. J., Lee, S. Y., Kim, S. R., Park, S. U., & Park, C. H. (2023). The Effect of Light and Dark Treatment on the Production of Rosmarinic Acid and Biological Activities in Perilla frutescens Microgreens. Plants, 12(8), 1613. https://doi.org/10.3390/plants12081613

